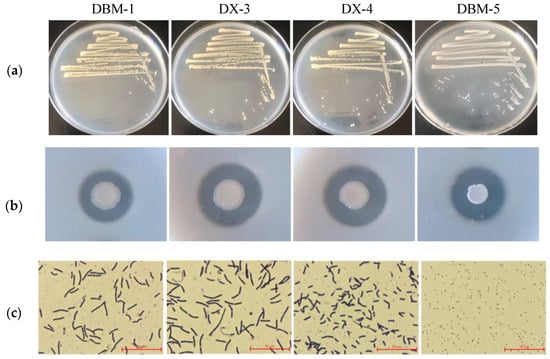

Simple Summary
This study employed microbial culturing to isolate four strains of bacteria with protease activity from the gut of an omnivorous insect. The four bacteria were precisely identified using whole-genome relatedness indices, based on conventional bacterial species identification methods. Furthermore, their whole-genome functional information was analyzed and compared, establishing a technical foundation for the development and utilization of protease-producing microorganisms from the insect gut.
Abstract
The insect gut harbors a diverse array of functional microorganisms that warrant further exploration and utilization. However, there is currently a paucity of research reports on the discovery of protease-producing microorganisms with industrial application value in the gut. Here, we employed microbial culturing to screen and identify the protease-producing microorganisms in the gut extract of Gryllotalpa orientalis. Based on morphological, physiological, and biochemical characterization, 16S rRNA sequencing, as well as ANI and dDDH values of whole genome, the protease-producing strains isolated from the insect gut were identified as Priestia aryahattai DBM-1 and DX-4, P. megaterium DX-3, and Serratia surfactantfaciens DBM-5. According to whole-genome analysis, strain DBM-5, which exhibited the highest enzyme activity, possesses abundant membrane transport genes and carbohydrate metabolism enzymes. In contrast, strains DX-3 and DX-4 not only have the ability to hydrolyze proteins but also demonstrate the capability to hydrolyze plant materials. Furthermore, strains that are closely related tend to have similar metabolic product gene clusters in their genomes. The screening and identification of protease resources are essential for the subsequent development and utilization of gut functional microorganisms and genetic resources in insects.
1. Introduction
The gut of insects is rich in microbial resources, serving as a resource pool for exploring functional and active substances [1]. As more and more biological characteristics of gut microbiota were being uncovered, there was a growing exploration and utilization of potential functional microorganisms and their functional genes [2,3]. The provision of abundant nutrients by functional microorganisms to insects may play a critical role in the formation of mutually beneficial relationships in biological evolution [1]. This was achieved through the secretion of various necessary hydrolytic enzymes for nutrient decomposition, digestion, and absorption, ensuring a sufficient nutritional supply [4]. Microbial enzymes have been widely utilized across various industries [5,6] due to their environmental friendliness, potential catalytic ability, capacity to optimize production processes, and capability for in vitro expression through gene recombination and protein engineering [7]. The exploration of microbial enzyme resources will be a pivotal focus in modern industrial biotechnology [8].
Currently, there have been reports of enzyme-producing microorganisms in the gut of various insects, such as the gut of termites, which were abundant in resources of lignocellulose-degrading microorganisms [9]. The gut microbiota of Tenebrio molitor larvae demonstrate a superior ability in the biodegradation of cellulose, polyethylene, and polystyrene waste [10,11]. Several trypsin- and chymotrypsin-like proteases have been identified in Periplaneta americana, exhibiting high activity at alkaline pH levels, thus demonstrating significant potential for industrial applications [12,13]. However, there has been limited research on the screening and identification of gut microorganisms in Orthoptera. Most existing studies have focused on the structure and function of gut microbial communities in Orthoptera [14,15]. Meanwhile, microbial proteases have a wide range of applications including for the clean production of leather, flavor enhancement of food, washing aids, and silk degumming processes [16,17]. Therefore, isolating protease-producing microorganisms from the insect gut will enhance the available resources for protease application.
The Gryllotalpidae belongs to the taxon of Orthoptera and is considered one of the most distinctive groups within Orthoptera due to its unique appearance. Gryllotalpa orientalis are omnivorous soil-dwelling pests that primarily feed on the roots and stems of seedlings. Additionally, they also consume soil invertebrates such as insects and earthworms, indicating a high presence of animal and plant proteolytic enzymes in their gut [18]. This study utilized microbial culturing to screen protease-producing microorganisms from the gut of the G. orientalis [19]. The identified strains were characterized through morphological observation, physiological and biochemical characteristics, and 16S rRNA gene and whole-genome sequencing in order to explore enzymatic microbial resources from the insect gut [20].
2. Materials and Methods
2.1. Insects’ Collection and Dissection
G. orientalis were collected from a farmland in Quyang County, Hebei Province, China. The body surface of the adult insects was disinfected with 75% alcohol, then rinsed thrice with sterile water, and then dissected under sterile conditions. The sterilized gut of each insect was then extracted and placed in 0.5 mL of PBS sterile buffer solution, with a pH of 7.2–7.4, containing one sterile steel ball. Under ice bath conditions, the gut samples were intermittently shaken until the gut tissue and contents were broken down, after which the steel balls were removed under sterile conditions [21,22]. The gut sample solution was centrifuged for 30 s at 1520× g at 4 °C. Subsequently, the supernatant was subjected to serial dilutions from 10−1 to 10−6 with PBS sterile buffer solution, resulting in a pH of 7.2–7.4. Following this, 100 μL of each diluted gut contents were evenly spread onto the corresponding protease-producing primary screening solid culture medium with the following composition (g/L): casein (10), peptone (2), yeast powder (1), NaCl (2), agar powder (15), pH 7.0–7.2 [23,24]. The gut bacteria were then cultured in this culture media at 37 °C for 48 h, with three replicates for each dilution.
2.2. Screening of Proteolytic Bacteria
The strain which exhibited a hydrolysis circle around the colony in the protease primary screening medium indicated its capability to produce protease and hydrolyze casein. Such colonies were selected and repeatedly cultured at 37 °C in the secondary screening medium (skimmed milk powder 20 g/L, agar powder 20 g/L, pH 7.0–7.2) [25] until a single colony with a transparent ring appeared; then, the strain was preserved [26].
2.3. Morphological, Physiological, Biochemical, and Molecular Identification of Bacteria
The morphological observation of proteolytic bacteria was performed using Gram staining and a series of physiological and biochemical tests on the above bacteria, including the macromolecular material hydrolysis test (gelatin, starch, glycerol, etc.), sugar (alcohol) fermentation test, IMViC test [27] (indole test, hydrogen sulfide test, VP test, citrate test, etc. were conducted.
The genomic DNA of bacteria was extracted for molecular identification. The 16S rRNA gene sequence was amplified using universal primers 27F (5′-AGTTTGATCMTG GCTCAG-3′) and 1492R (5’-GGTTACCTTGTTACGACTT-3′) [28]. The amplified products were sequenced through commercial services provided by Sangon Biotech Co., Ltd. (Shanghai, China). The comparison of sequencing results was performed by BLAST through NCBI’s 16S ribosomal RNA sequences database (Bacteria and Archaea), using the Cluster W program of MEGA for multiple sequence alignment. Then, a phylogenetic tree was constructed by the neighbor-joining model of the MEGA 11.0 [29,30].
2.4. Whole-Genome Analysis of Proteolytic Bacteria
Bacterial cell suspensions in LB broth at the logarithmic growth phase were harvested. Genomic DNA was then extracted using magnetic beads, and the bacterial genomes was sequenced through commercial services provided by Sangon Biotech Co., Ltd. (Shanghai, China). Subsequently, genomes were constructed, and high-throughput sequencing was performed on the Illumina HiSeq sequencing platform [11]. The original sequencing data was evaluated and controlled through Fastp [31]. SPAdes [32] was utilized to assemble the sequencing data, and GapFiller [33] was employed to fill in gaps in the concatenated contig. Afterward, Pilon (https://github.com/broadinstitute/pilon, accessed on 22 July 2023) was used for sequence correction to complete genome splicing. Firstly, the evolutionary status of proteolytic bacteria was inferred based on the 16S rRNA gene sequence. Subsequently, OAT 0.93.1 (Orthologous Average Nucleotide Identity Tool, https://www.ezbiocloud.net/tools/orthoani, accessed on 2 August 2023) software was used to analyze the characteristics of ANI (Average nucleotide identity) value across the entire genome of strains [34], and genome-to-genome distance calculator 2.1 (https://ggdc.dsmz.de/, accessed on 6 September 2023) was used to calculate the dDDH (Digital DNA–DNA hybridization) value [35], in order to determine the taxonomic relationship of the proteolytic strains based on their genome sequence. NCBI-PGAP conducts genome analysis and predicts gene elements, including CDS, tRNA, and rRNA. The gene sequences were compared with multiple databases such as NR (http://ncbi.nlm.nih.gov/, accessed on 23 July 2023), COG (https://www.ncbi.nlm.nih.gov/COG/, accessed on 27 July 2023), PFAM (http://pfam.xfam.org/, accessed on 27 July 2023), GO (https://geneontology.org/, accessed on 29 July 2023), KEGG (http://www.kegg.jp, accessed on 29 July 2023), CAZy (http://www.cazy.org/, accessed on 27 July 2023), and CARD (https://card.mcmaster.ca/, accessed on 27 July 2023) using blastp with an evaluation threshold of ≤1 × 10−5 to obtain gene functional annotation information. Differential analysis of functional gene clusters among four proteolytic strains was performed using antiSMASH (https://antismash.secondarymetabolites.org/, accessed on 15 August 2023). Based on the Expasy database (https://enzyme.expasy.org/index.html, accessed on 13 August 2024), information on various types of proteases was retrieved. Then, the protease genes and their corresponding species were selected from the annotation results of strains in the KEGG ENZYME database based on this protease information.
3. Results
3.1. Screening and Identification of Proteolytic Bacteria
A total of 15 proteolytic bacteria were isolated from the gut extracts of G. orientalis. Among these, four strains exhibited higher protease activity and were designated as DBM-1, DX-3, DX-4, and DBM-5. According to the primary screening medium (Figure 1a), the colony morphology of strains DBM-1, DX-3, and DX-4 was similar—milky white, opaque, circular, with wrinkles on the edges. Strain DBM-5 was milky white and semitransparent with a smooth surface and raised center. Hydrolysis of the culture medium was evident around the DBM-5 colony, and red appeared around the colony as the cultivation time prolonged (Figure S1). The ratio of the transparent circle to the diameter of the colony in the secondary screening medium represents the ability of the strain to produce protease (Figure 1b). The strain which exhibited the most substantial enzyme production ability was DBM-5, followed by strains DX-3 and DX-4, and the strain with the weakest enzyme production ability was strain DBM-1. In microscopic morphology (Figure 1c), the strain DBM-5 appeared relatively smaller in comparison to the other three strains.
Figure 1.
Screening of proteolytic bacteria in the gut of G. orientalis. (a) Screening with primary screening medium; (b) Characterization of protease production characteristics of strains using secondary screening medium; (c) Microscopic observation of the strain.
The physiological and biochemical analysis of proteolytic bacteria (Tables S1 and S2) revealed a strong ability to utilize carbohydrates in strains DBM-1, DX-3, and DX-4. In contrast to strains DBM-1 and DX-4, strain DX-3 exhibited limited hydrolysis capability in glycerol, D-lactose, D-galactose, and D-Toulon sugar. However, it demonstrated a unique ability to hydrolyze D-melezitose. Strain DX-4 demonstrated a higher capacity for hydrolyzing L-rhamnose, inositol, and α- methyl-D glucoside. In contrast, strain DBM-5 exhibited the ability to ferment various sugars and alcohols, produce acid, and secrete some hydrolytic enzymes.
Multiple sequence alignment was conducted for homologous sequences of four proteolytic strains, and unrooted evolutionary trees based on the 16S rRNA gene were constructed (Figure 2a,b). The closest relative to strains DBM-1 and DX-4 was Priestia aryahattai B8W22, while strain DX-3 showed the closest evolutionary distance to P. megaterium NBRC 15308, and strain DBM-5 had the closest evolutionary distance to Serratia marcescens NBRC 102204. Based on the morphology, physiological and biochemical experiments, 16S rDNA sequence alignment, and phylogenetic analysis, it was speculated that strains DBM-1 and DX-4 were classified as P. aryabhattai, strain DX-3 as P. megaterium, and strain DBM-5 as S. marcescens.

Figure 2.
Unrooted evolutionary tree based on neighbor-joining of 16S rRNA gene of the strains in the gut of G. orientalis. (a) Unrooted evolutionary tree of strains DBM-1, DX-3, and DX-4; (b) Unrooted evolutionary tree of strain DBM-5.
3.2. Analysis of Proteolytic Bacteria through Whole-Genome Sequencing
Based on the identification results of 16S rRNA gene sequencing, strains with close genetic relationships were screened for genomic ANI and dDDH values (Table 1 and Figure 3). The thresholds for ANI and dDDH were set at 95–96% and 70%, respectively, in accordance with the criteria for species differentiation [36]. The genome of strains DBM-1 and DX-4 were found to be most similar to the reference strain of P. aryabhattai UASWS 1812-B29, with ANI values of over 98% and dDDH values of over 91%. Although the ANI and dDDH values shared by strains DBM-1 and DX-4 with P. megaterium also exceed the same threshold, their values with P. aryabhattai were significantly higher than those of P. megaterium. Therefore, it was concluded that strains DBM-1 and DX-4 belong to the species P. aryabhattai. The genome of strain DX-3 was found to be most similar to P. megaterium P-NA14, leading to the conclusion that strain DX-3 belongs to the species P. megaterium. The genome identification results of strains DBM-1, DX-3, and DX-4 were consistent with the 16S rRNA gene sequence identification. According to the 16S rRNA gene identification, it was determined that there is a close genetic relationship between strains DBM-5 and S. marcescens. However, in whole-genome identification, it was observed that the ANI and dDDH values of strain DBM-5 and S. marcescens did not reach the same threshold, instead they shared 99.48% of the ANI value and 96.3% of the dDDH value with S. surfactantfaciens YD25. Therefore, DBM-5 was concluded to be S. surfactantfaciens.

Table 1.
The dDDH value of genome comparison between proteolytic bacteria and similar strains.

Figure 3.
The ANI values of genome comparison between proteolytic bacteria and similar strains. (a) Genome ANI values of strains DBM-1, DX-3, and DX-4; (b) Genome ANI values of strain DBM-5. Notes: Different colors correspond to different levels of ANI values, with red indicated high ANI values and blue indicated low ANI values.
The strain DX-4 possessed the largest genome, with a total length of 5,135,523 bp and the highest predicted number of coding genes (CDS) at 5222. However, it also had the lowest proportion of CDS gene length to genome length. The strain DBM-5 comprised the highest GC content. Overall, the number of tRNAs in the non-coding RNA of the four strains was higher than that of the other RNA, with strain DX-3 having the highest number of tRNAs (Table 2).

Table 2.
Sequencing results date statistics of proteolytic bacteria.
The annotated gene ratios predicted by the genome sequencing of four strains through databases such as NR, COG, PFAM, GO, KEGG, CAZy, and CARD were presented in Figure S2. The NR database has the highest annotated ratio, with over 99.88% of genes successfully annotated. Strain DX-3 showed a higher gene annotation ratio in the COG, PFAM, GO, KEGG, CAZy, and CARD databases compared to the other three strains, especially in GO databases. Moreover, the gene annotation ratio was three times higher than other strains.
Strains DBM-1, DX-3, and DX-4 have 713, 863, and 729 gene annotations in the GO database, respectively. All these strains annotate 33 functional classifications. In contrast, strain DBM-5 had a total of 2282 gene annotations, which cover 39 functional classifications (Figure S3). The genomes of these four strains exhibit the highest number of annotated genes in the biological process (BP) functional classification of the GO database, which was consistent. Cellular processes (GO: 0009987) and metabolic processes (GO: 0008152) were the central pathways in BP. The main pathway in molecular function (MF) was catalytic activity (GO: 0003824), while the main pathway in cellular component (CC) was membrane (GO: 0016020).
Strains DBM-1, DX-3, DX-4, and DBM-5 have 1226, 1308, 1258, and 1580 genes annotated in the KEGG database, respectively (Figure 4). The number of genes annotated to the metabolism pathway was the highest, mainly enriched in carbohydrate metabolism and amino acid metabolism. The second highest was the environmental information processing pathway, mainly enriched in the membrane transport pathway. Notably, the genome of strain DBM-5 contained twice as many membrane transport genes compared to other strains. In the genetic information processing pathway, the number of genes involved in the transcription and translation pathways in the genomes of strains DX-3 and DBM-5 was significantly higher than in strains DBM-1 and DX-4.

Figure 4.
KEGG functional annotation of the genome of proteolytic bacteria.
Strains DBM-1, DX-3, DX-4, and DBM-5 have 74, 80, 79, and 100 genes annotated in the CAZy database, respectively (Figure S4). Among them, the largest number of genes were annotated to glycosyl transferases (GTs), followed by glycoside hydrolases (GHs). Strain DBM-5 exhibited a higher number of genes annotated to GTs, GHs, carbohydrate esterases (CEs), and auxiliary activities (AAs) compared to other strains. However, only polysaccharide lyases (PLs) were annotated in strains DX-3 and DX-4 genomes. The representative carbohydrate enzyme was pectate lyase (EC 4.2.2.2), which is involved in hydrolyzing the polysaccharides found in plant cell walls, suggested that strains DX-3 and DX-4 were also capable of breaking down plant materials [37].
The genomes of strains DBM-1, DX-3, DX-4, and DBM-5 predicted eight, six, eight, and nine secondary metabolite gene clusters, respectively [38] (Table 3). The main types of metabolites include terpene, lassopeptide, type III polyketide synthase (T3PKS), and non-ribosomal peptide synthase (NRPS), which participated in encoding surfactants, carotenoids, and non-ribosomal lipopeptides. It was observed that the predicted metabolites of the eight gene clusters in the genomes of strains DBM-1 and DX-4 were consistent; however, there were slight differences in similarity with known gene clusters. Additionally, all six predicted gene clusters in the genome of strain DX-3 were included in the gene clusters of strains DBM-1 and DX-4 but did not contain lanthiopeptide-class-i and phosphonate. Furthermore, the genome of strain DBM-5 was found to predict a completely different metabolic product gene cluster from other strains, with the primary metabolic product type being non-ribosomal peptide synthase (NRPS).

Table 3.
Predicted biosynthesis clusters of proteolytic bacteria.
We retrieved information on various types of proteases, including serine protease, pepsin, trypsin, cysteine protease, and metalloprotease from the Expasy database. Subsequently, we conducted a comparison and analysis of this information with the annotation results of the strain genome in KEGG ENZYME database. The results (Table 4) indicated that strains DBM-1, DX-3, DX-4, and DBM-5 harbored three, three, three, and four protease gene sequences, respectively. These sequences corresponded to serine protease, pepsin, and trypsin; however, no data regarding cysteine protease or metalloprotease were found in these strains. Notably, strain DBM-5 exhibited two distinct types of annotated trypsin within its genome.

Table 4.
Identification of protease genes in bacterial genomes.
4. Discussion
Cultivation of microbial technology is a traditional method for studying the interaction between hosts and symbiotic microorganisms, as well as for exploring functional genes. However, due to the large population of herbivorous insects [2], research on gut functional microorganisms mainly focuses on screening and identifying the microorganisms that hydrolyze lignin and cellulose [39,40]. While microbial proteases are important industrial enzymes, there have been few reports on the research of proteases derived from insect guts. Especially in Orthoptera, research on gut microorganisms has mostly focused on the structure, function, and relationship with the host life activities of the gut microbiota. This study utilized a selective culture medium to screen for proteolytic bacteria from the gut of G. orientalis, which was beneficial for exploring the functional microbial resources derived from the gut of Orthoptera. Four protease-producing microorganisms were preliminarily screened and identified in the gut of G. orientalis. Among these, P. megaterium was identified as an important enzyme-producing strain capable of producing various enzymes such as proteases, cellulases, oxidases, polysaccharide-degrading enzymes, extracellular agarases, etc. [41]. The probiotic properties of this bacterium play a positive role in maintaining gut health, and this study was the first to screen for the gut-derived P. megaterium that produces protease [42].
Identification and classification are two of the most important aspects of microbiology. The current phylogeny of prokaryotes is based on the 16S rRNA gene sequence (≥99%) [43]. However, the highly conserved sequence of the 16S rRNA gene limits the accuracy of species identification in prokaryotic diversity. Therefore, it is imperative to make improvements in this area to enhance the accuracy and specificity of species identification [44]. Raman spectroscopy, single genes, multigene, SNPs, and core-genome sequences [45] have emerged as powerful methods for microbial identification. However, whole-genome sequencing analysis [46] has been gradually applied to studying bacterial classification, evolution, and functional genes due to its superior ability to comprehend bacterial genomic information. Additionally, the assessment of inter-strain correlation based on whole-genome sequence ANI values (≥95%) and dDDH values (≥ 70%) has become a new gold standard for inter-species molecular identification [36]. This study preliminarily identified the taxonomic status of protease-producing strains using morphological, physiological and biochemical characteristics, as well as 16S rRNA gene sequencing. Furthermore, the species information of four strains was accurately identified based on whole-genome ANI and dDDH values [34,47]. Although the ANI and dDDH values of P. aryabhattai and P. megaterium initially classified under Bacillus exceeded the threshold; however, specific values can be used to determine differences between strains. To further clarify the functional information of the strains, whole-genome sequencing was utilized to comprehensively characterize the genetic basis of the strains, including genome composition, functional classification, and secondary metabolite synthesis gene clusters. Additionally, we investigated the protease gene information within the genomes of the strains and observed that strain DBM-5 possessed a greater variety of proteases compared to the other strains. This observation was consistent with the elevated protease activity identified during the screening of strain DBM-5.
5. Conclusions
This study represents the first attempt to isolate protease-producing bacteria from the gut of G. orientalis. Four novel proteolytic bacteria were screened and identified as P. aryahattai DBM-1 and DX-4, P. megaterium DX-3, and S. surfactantfaciens DBM-5. Among them, the strain DBM-5 possesses abundant membrane transport genes and carbohydrate metabolism enzymes. Strains DX-3 and DX-4 not only demonstrate the ability to hydrolyze proteins but also exhibit proficiency in hydrolyzing plant materials.
Supplementary Materials
The following supporting information can be downloaded at: https://www.mdpi.com/article/10.3390/insects15080629/s1, Figure S1: Morphological observation of strain DBM-5 in protease producing screening medium with prolonged cultivation time. (a) Cultivate for 24 h; (b) Cultivate for 48 h; (c) Cultivate for 7 days; Figure S2: Morphological observation of strain DBM-5 in protease producing screening medium with prolonged cultivation time; Figure S3: GO functional annotation of the genome of proteolytic bacteria; Figure S4: CAZymes functional annotation of the genome of proteolytic bacteria; Table S1: Analysis of physiological and biochemical characteristics of proteolytic bacteria; Table S2: Analysis of physiological and biochemical characteristics of proteolytic bacteria.
Author Contributions
X.Z.: Conceptualization, Formal Analysis, Investigation, Data Curation, Visualization, Writing—Original Draft and Funding Acquisition. L.Z.: Methodology, Data Curation, and Formal Analysis. F.W.: Methodology, Validation, and Writing—Original Draft. H.Z.: Software and Visualization. F.S.: Conceptualization, Methodology, Project Administration, Resources, Supervision and Writing—Review and Editing. All authors have read and agreed to the published version of the manuscript.
Funding
This research was funded by the Science and Technology Project of Hebei Academy of Sciences (Grant No. 2022Q2).
Data Availability Statement
The assembled genomes were submitted to GenBank Database (accession number: GCA_037164005.1; GCA_037163955.1; GCA_037164135.1; GCA_037163965.1). The raw sequencing data was submitted to NCBI SRA database (accession number: PRJNA1063775; PRJNA1060919; PRJNA1063778; PRJNA1063541).
Conflicts of Interest
Author Xiang Zheng, Lu Zhao, Fangtong Wu, and He Zhou were employed by the company Hebei Research Institute of Microbiology Co., Ltd. The remaining authors declare that the research was conducted in the absence of any commercial or financial relationships that could be construed as a potential conflict of interest.
References
- Douglas, A.E. Multiorganismal insects: Diversity and function of resident microorganisms. Annu. Rev. Entomol. 2015, 60, 17–34. [Google Scholar] [CrossRef]
- Hatefi, A.; Makhdoumi, A.; Asoodeh, A.; Mirshamsi, O. Characterization of a bi-functional cellulase produced by a gut bacterial resident of rosaceae branch borer beetle, Osphranteria coerulescens (Coleoptera: Cerambycidae). Int. J. Biol. Macromol. 2017, 103, 158–164. [Google Scholar] [CrossRef] [PubMed]
- Shi, W.; Ding, S.-Y.; Yuan, J.S. Comparison of insect gut cellulase and xylanase activity across different insect species with distinct food sources. Bioenergy Res. 2010, 4, 1–10. [Google Scholar] [CrossRef]
- Ankrah, N.Y.D.; Douglas, A.E. Nutrient factories: Metabolic function of beneficial microorganisms associated with insects. Environ. Microbiol. 2018, 20, 2002–2011. [Google Scholar] [CrossRef] [PubMed]
- Krishnan, M.; Bharathiraja, C.; Pandiarajan, J.; Prasanna, V.A.; Rajendhran, J.; Gunasekaran, P. Insect gut microbiome—An unexploited reserve for biotechnological application. Asian Pac. J. Trop. Biomed. 2014, 4, S16–S21. [Google Scholar] [CrossRef] [PubMed]
- Solanki, P.; Putatunda, C.; Kumar, A.; Bhatia, R.; Walia, A. Microbial proteases: Ubiquitous enzymes with innumerable uses. 3 Biotech. 2021, 11, 428. [Google Scholar] [CrossRef]
- Banerjee, S.; Maiti, T.K.; Roy, R.N. Enzyme producing insect gut microbes: An unexplored biotechnological aspect. Crit. Rev. Biotechnol. 2022, 42, 384–402. [Google Scholar] [CrossRef] [PubMed]
- Wang, K.; Gao, P.; Geng, L.; Liu, C.; Zhang, J.; Shu, C. Lignocellulose degradation in Protaetia brevitarsis larvae digestive tract: Refining on a tightly designed microbial fermentation production line. Microbiome 2022, 10, 90. [Google Scholar] [CrossRef]
- Hori, C.; Song, R.; Matsumoto, K.; Matsumoto, R.; Minkoff, B.B.; Oita, S.; Hara, H.; Takasuka, T.E. Proteomic characterization of lignocellulolytic enzymes secreted by the insect-associated fungus Daldinia decipiens oita, isolated from a forest in northern japan. Appl. Environ. Microbiol. 2020, 86, e02350-19. [Google Scholar] [CrossRef]
- Przemieniecki, S.W.; Kosewska, A.; Ciesielski, S.; Kosewska, O. Changes in the gut microbiome and enzymatic profile of Tenebrio molitor larvae biodegrading cellulose, polyethylene and polystyrene waste. Environ. Pollut. 2020, 256, 113265. [Google Scholar] [CrossRef]
- Zhang, Z.; Peng, H.; Yang, D.; Zhang, G.; Zhang, J.; Ju, F. Polyvinyl chloride degradation by a bacterium isolated from the gut of insect larvae. Nat. Commun. 2022, 13, 5360. [Google Scholar] [CrossRef] [PubMed]
- Hivrale, V.K.; Chougule, N.P.; Chhabda, P.J.; Giri, A.P.; Kachole, M.S. Unraveling biochemical properties of cockroach (Periplaneta americana) proteinases with a gel X-ray film contact print method. Comp. Biochem. Physiol. B 2005, 141, 261–266. [Google Scholar] [CrossRef] [PubMed]
- Hivrale, V.K.; Lomate, P.R.; Kalve, N.D.; Kachole, M.S. Periplaneta americana midgut proteases differentially expressed against dietary components from different plant seeds. Physiol. Entomol. 2011, 36, 180–186. [Google Scholar] [CrossRef]
- Ng, S.H.; Stat, M.; Bunce, M.; Simmons, L.W. The influence of diet and environment on the gut microbial community of field crickets. Ecol. Evol. 2018, 8, 4704–4720. [Google Scholar] [CrossRef] [PubMed]
- Lavy, O.; Gophna, U.; Gefen, E.; Ayali, A. Dynamics of bacterial composition in the locust reproductive tract are affected by the density-dependent phase. FEMS Microbiol. Ecol. 2020, 96, fiaa044. [Google Scholar] [CrossRef]
- Kannan, M.; Ramya, T.; Anbalagan, S.; Suriya, J.; Krishnan, M. Proteomic analysis of pupal gut serine protease of silkworm, Bombyx mori: Partial purification and biochemical characterization. Biocatal. Agric. Biotechnol. 2017, 12, 159–165. [Google Scholar] [CrossRef]
- Foroughi, F.; Keshavarz, T.; Evans, C.S. Specificities of proteases for use in leather manufacture. J. Chem. Technol. Biotechnol. 2006, 81, 257–261. [Google Scholar] [CrossRef]
- Banerjee, S.; Maiti, T.K.; Roy, R.N. Protease production by thermo-alkaliphilic novel gut isolate Kitasatospora cheerisanensis gap 12.4 from Gryllotalpa africana. Biocatal. Bioransform. 2017, 35, 168–176. [Google Scholar] [CrossRef]
- Vilcinskas, A.; Schwabe, M.; Brinkrolf, K.; Plarre, R.; Wielsch, N.; Vogel, H. Larvae of the clothing moth Tineola bisselliella maintain gut bacteria that secrete enzyme cocktails to facilitate the digestion of keratin. Microorganisms 2020, 8, 1415. [Google Scholar] [CrossRef]
- Liu, Q.; Zhang, T.; Song, N.; Li, Q.; Wang, Z.; Zhang, X.; Lu, X.; Fang, J.; Chen, J. Purification and characterization of four key enzymes from a feather-degrading Bacillus subtilis from the gut of tarantula Chilobrachys guangxiensis. Int. Biodeterior. Biodegrad. 2014, 96, 26–32. [Google Scholar] [CrossRef]
- Jiang, S.; Su, T.; Zhao, J.; Wang, Z. Isolation, identification, and characterization of polystyrene-degrading bacteria from the gut of Galleria mellonella (Lepidoptera: Pyralidae) larvae. Front. Bioeng. Biotechnol. 2021, 9, 736062. [Google Scholar] [CrossRef] [PubMed]
- Suman, S.K.; Dhawaria, M.; Tripathi, D.; Raturi, V.; Adhikari, D.K.; Kanaujia, P.K. Investigation of lignin biodegradation by Trabulsiella sp. Isolated from termite gut. Int. Biodeterior. Biodegrad. 2016, 112, 12–17. [Google Scholar] [CrossRef]
- Rehman, R.; Ahmed, M.; Siddique, A.; Hasan, F.; Hameed, A.; Jamal, A. Catalytic role of thermostable metalloproteases from Bacillus subtilis kt004404 as dehairing and destaining agent. Appl. Biochem. Biotechnol. 2017, 181, 434–450. [Google Scholar] [CrossRef]
- Gao, S.; Pan, L.; Zhang, M.; Huang, F.; Zhang, M.; He, Z. Screening of bacterial strains from the gut of pacific white shrimp (Litopenaeus vannamei) and their efficiencies in improving the fermentation of soybean meal. FEMS Microbiol. Lett. 2020, 367, fnaa017. [Google Scholar] [CrossRef] [PubMed]
- Ji, Z.L.; Peng, S.; Chen, L.L.; Liu, Y.; Yan, C.; Zhu, F. Identification and characterization of a serine protease from Bacillus licheniformis w10: A potential antifungal agent. Int. J. Biol. Macromol. 2020, 145, 594–603. [Google Scholar] [CrossRef] [PubMed]
- Zhang, K.; Huang, Q.Q.; Li, Y.; Liu, L.H.; Tango, X.F.; Tang, B. Maturation process and characterization of a novel thermostable and halotolerant subtilisin-like protease with high collagenolytic activity but low gelatinolytic activity. Appl. Environ. Microb. 2022, 88, e02184-21. [Google Scholar] [CrossRef]
- Chauhan, J.V.; Mathukiya, R.P.; Singh, S.P.; Gohel, S.D. Two steps purification, biochemical characterization, thermodynamics and structure elucidation of thermostable alkaline serine protease from Nocardiopsis alba strain om-5. Int. J. Biol. Macromol. 2021, 169, 39–50. [Google Scholar] [CrossRef]
- Holger, H.; Martin, K.; Paul, B.; Kornelia, S.; Elizabeth, M.H.W. Analysis of actinomycete communities by specific amplification of genes encoding 16s rrna and gel-electrophoretic separation in denaturing gradients. Appl. Environ. Microb. 1997, 63, 3233–3241. [Google Scholar]
- Li, F.; Xie, Y.; Gao, X.; Shan, M.; Sun, C.; Niu, Y.D.; Shan, A. Screening of cellulose degradation bacteria from min pigs and optimization of its cellulase production. Electron. J. Biotechnol. 2020, 48, 29–35. [Google Scholar] [CrossRef]
- Marynowska, M.; Goux, X.; Sillam-Dusses, D.; Rouland-Lefevre, C.; Halder, R.; Wilmes, P.; Gawron, P.; Roisin, Y.; Delfosse, P.; Calusinska, M. Compositional and functional characterisation of biomass-degrading microbial communities in guts of plant fibre- and soil-feeding higher termites. Microbiome 2020, 8, 96. [Google Scholar] [CrossRef]
- Chen, S.; Zhou, Y.; Chen, Y.; Gu, J. Fastp: An ultra-fast all-in-one fastq preprocessor. Bioinformatics 2018, 34, i884–i890. [Google Scholar] [CrossRef]
- Bankevich, A.; Nurk, S.; Antipov, D.; Gurevich, A.A.; Dvorkin, M.; Kulikov, A.S.; Lesin, V.M.; Nikolenko, S.I.; Pham, S.; Prjibelski, A.D.; et al. Spades: A new genome assembly algorithm and its applications to single-cell sequencing. J. Comput. Biol. 2012, 19, 455–477. [Google Scholar] [CrossRef] [PubMed]
- Boetzer, M.; Pirovano, W. Toward almost closed genomes with gapfiller. Genome Biol. 2012, 13, R56. [Google Scholar] [CrossRef] [PubMed]
- Volpiano, C.G.; Sant’Anna, F.H.; Ambrosini, A.; de São José, J.F.B.; Beneduzi, A.; Whitman, W.B.; de Souza, E.M.; Lisboa, B.B.; Vargas, L.K.; Passaglia, L.M.P. Genomic metrics applied to Rhizobiales (Hyphomicrobiales): Species reclassification, identification of unauthentic genomes and false type strains. Front. Microbiol. 2021, 12, 614957. [Google Scholar] [CrossRef]
- Velez, L.S.; Aburjaile, F.F.; Farias, A.R.G.; Baia, A.D.B.; Oliveira, W.J.; Silva, A.M.F.; Benko-Iseppon, A.M.; Azevedo, V.; Brenig, B.; Ham, J.H.; et al. Burkholderia semiarida sp. Nov. and burkholderia sola sp. Nov., two novel B. cepacia complex species causing onion sour skin. Syst. Appl. Microbiol. 2023, 46, 126415. [Google Scholar] [CrossRef]
- Lindsey, R.L.; Gladney, L.M.; Huang, A.D.; Griswold, T.; Katz, L.S.; Dinsmore, B.A.; Im, M.S.; Kucerova, Z.; Smith, P.A.; Lane, C.; et al. Rapid identification of enteric bacteria from whole genome sequences using average nucleotide identity metrics. Front. Microbiol. 2023, 14, 1225207. [Google Scholar] [CrossRef] [PubMed]
- Kannan, M.; Mubarakali, D.; Thiyonila, B.; Krishnan, M.; Padmanaban, B.; Shantkriti, S. Insect gut as a bioresource for potential enzymes—An unexploited area for industrial biotechnology. Biocatal. Agric. Biotechnol. 2019, 18, 101010. [Google Scholar] [CrossRef]
- Alam, K.; Zhao, Y.; Lu, X.; Gong, K.; Zhong, L.; Hao, J.; Islam, M.M.; Islam, S.; Li, G.; Zhang, Y.; et al. Isolation, complete genome sequencing and in silico genome mining of Burkholderia for secondary metabolites. BMC Microbiol. 2022, 22, 323. [Google Scholar] [CrossRef]
- Willis, J.D.; Klingeman, W.E.; Oppert, C.; Oppert, B.; Jurat-Fuentes, J.L. Characterization of cellulolytic activity from digestive fluids of Dissosteira carolina (Orthoptera: Acrididae). Comp. Biochem. Physiol. B Biochem. Mol. Biol. 2010, 157, 267–272. [Google Scholar] [CrossRef]
- Finlayson-Trick, E.C.L.; Getz, L.J.; Slaine, P.D.; Thornbury, M.; Lamoureux, E.; Cook, J.; Langille, M.G.I.; Murray, L.E.; McCormick, C.; Rohde, J.R.; et al. Taxonomic differences of gut microbiomes drive cellulolytic enzymatic potential within hind-gut fermenting mammals. PLoS ONE 2017, 12, e0189404. [Google Scholar] [CrossRef]
- Thanh Ha, D.T.; Kim Thoa, L.T.; Phuong Thao, T.T.; Dung, T.T.; Minh Ha, T.T.; Phuong Lan, T.T.; Khoo, K.S.; Show, P.L.; Huy, N.D. Production of extracellular agarase from Priestia megaterium at7 and evaluation on marine algae hydrolysis. Enzym. Microb. Technol. 2024, 172, 110339. [Google Scholar] [CrossRef] [PubMed]
- Simon, A.; Colom, J.; Mazhar, S.; Khokhlova, E.; Deaton, J.; Rea, K. Bacillus megaterium renuspore® as a potential probiotic for gut health and detoxification of unwanted dietary contaminants. Front. Microbiol. 2023, 14, 1125616. [Google Scholar] [CrossRef] [PubMed]
- Li, M.; Yang, L.-R.; Xu, G.; Wu, J.-P. Identification of organic solvent-tolerant lipases from organic solvent-sensitive microorganisms. J. Mol. Catal. B Enzym. 2014, 99, 96–101. [Google Scholar] [CrossRef]
- Santos, R.G.d.; Hurtado, R.; Rodrigues, D.L.N.; Lima, A.; dos Anjos, W.F.; Rifici, C.; Attili, A.R.; Tiwari, S.; Jaiswal, A.K.; Spier, S.J.; et al. Comparative genomic analysis of the Dietzia genus: An insight into genomic diversity, and adaptation. Res. Microbiol. 2023, 174, 103998. [Google Scholar] [CrossRef] [PubMed]
- Rasmussen, L.H.; Dargis, R.; Højholt, K.; Christensen, J.J.; Skovgaard, O.; Justesen, U.S.; Rosenvinge, F.S.; Moser, C.; Lukjancenko, O.; Rasmussen, S.; et al. Whole genome sequencing as a tool for phylogenetic analysis of clinical strains of mitis group streptococci. Eur. J. Clin. Microbiol. 2016, 35, 1615–1625. [Google Scholar] [CrossRef]
- Legein, M.; Wittouck, S.; Lebeer, S. Latilactobacillus fragifolii sp. Nov., isolated from leaves of a strawberry plant (Fragaria x ananassa). Int. J. Syst. Evol. Microbiol. 2022, 72, 005193. [Google Scholar] [CrossRef]
- Morimoto, Y.; Tohya, M.; Aibibula, Z.; Baba, T.; Daida, H.; Kirikae, T. Re-identification of strains deposited as Pseudomonas aeruginosa, Pseudomonas fluorescens and Pseudomonas putida in genbank based on whole genome sequences. Int. J. Syst. Evol. Microbiol. 2020, 70, 5958–5963. [Google Scholar] [CrossRef]
Disclaimer/Publisher’s Note: The statements, opinions and data contained in all publications are solely those of the individual author(s) and contributor(s) and not of MDPI and/or the editor(s). MDPI and/or the editor(s) disclaim responsibility for any injury to people or property resulting from any ideas, methods, instructions or products referred to in the content. |
© 2024 by the authors. Licensee MDPI, Basel, Switzerland. This article is an open access article distributed under the terms and conditions of the Creative Commons Attribution (CC BY) license (https://creativecommons.org/licenses/by/4.0/).